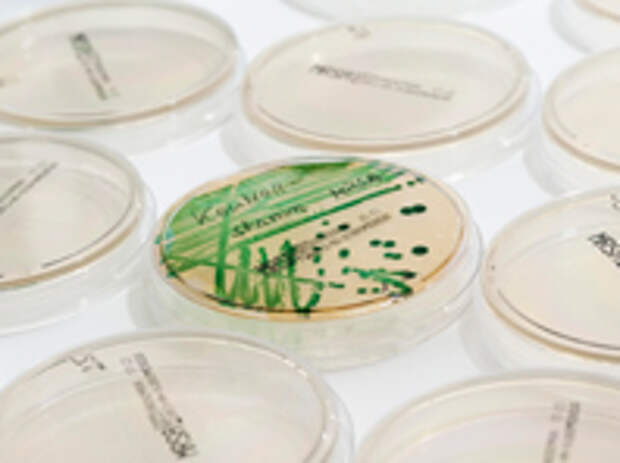

Российские специалисты презентовали свою разработку - новые соединения, способные побороть стафилококк, опасного возбудителя внутрибольничных инфекций. Изобретение принадлежит сотрудникам кафедры органической химии ПГНИУ, профессору Андрею Масливцу, старшему преподавателю Максиму Дмитриеву, Павлу Мелюхину и их коллегам из лаборатории "Бактерицид" химического факультета.
Ученые уже оформили патент на способ получения лекарственных соединений. Сообщается, что полученные вещества обладают значительно более выраженным бактерицидным эффектом в отношении золотистого стафилококка, чем распространенные в текущей медицинской практике антисептические препараты.
Запатентованные соединения уже протестировали на золотистом стафилококке, провоцирующем развитие целого набора заболеваний (от респираторных и кожных до заболеваний сердца и костного мозга). Согласно статистике, золотистый стафилококк - самая частая причина внутрибольничных инфекций и источник послеоперационных осложнений. Притом, до 50% людей являются носителями стафилококка.
Свежие комментарии